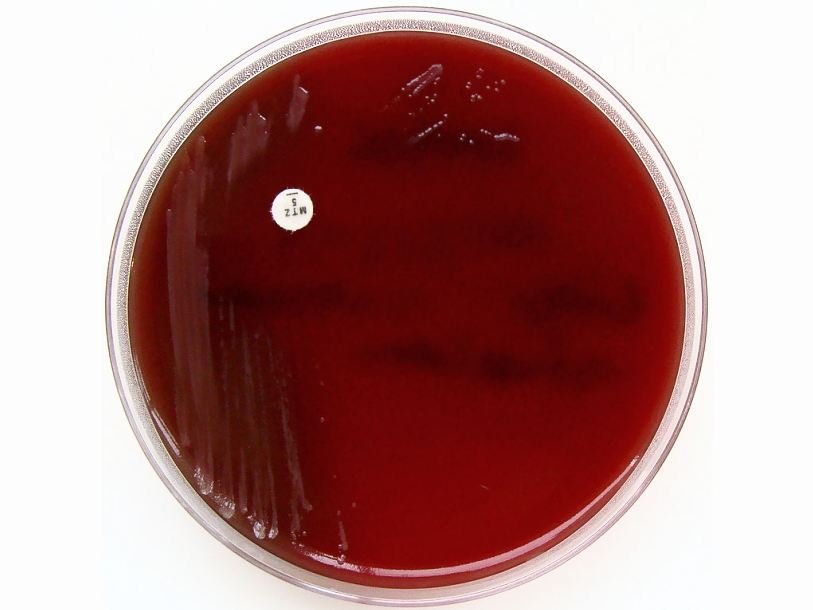

Обнаружилась связь между бактериями-симбионтами и аутизмом
Интеллектуальный партнер проекта Неожиданная связь между симбиотическими микробами, населяющими желудочно-кишечный тракт, и развитием аутизма обнаружилась в исследовании американских ученых.
В их работе мышата с симптомами аутизма появлялись на свет у матерей, которым в период беременности вводились синтетические вирусы. Подробнее о механизмах, связывающих вирусные заболевания матери во время беременности с расстройствами аутического спектра у потомства, уже рассказывалось в ProScience. Кроме поведенческих проблем, у таких мышей наблюдались аномалии в работе желудочно-кишечного тракта: была повышена проницаемость стенок кишечника. Похожая аномалия кишечника, по всей видимости, наблюдается и у детей, страдающих аутизмом. Исследовав кишечную микрофлору у мышей с симптомами аутизма, ученые обнаружили, что у них меньше бактерий Bacteroides fragilis, чем у здоровых мышей. После того, как популяция этих бактерий в кишечнике у мышей искусственно восстанавливалась, симптомы аутизма становились менее выраженными, а проницаемость стенок кишечника снижалась.
Следующая часть исследования была посвящена попыткам прояснить механизм влияния живущих в кишечнике бактерий на головной мозг. Благодаря гемато-энцефалическому барьеру непосредственно к клеткам головного мозга из кровяного русла могут проникать, в основном, небольшие молекулы. Для одной из таких молекул – 4-этилфенилсульфата – была обнаружена 46-кратная разница в концентрации в плазме крови аутичных и нормальных мышей. У аутичных вещества было больше. Примечательно, что повышенный уровень схожего вещества (4-метилфенилсульфата) обнаруживался в крови людей, страдающих аутизмом, и, вероятно, связан с более тяжелым течением болезни. Восстановление популяции B. fragilis приводило к нормализации уровня 4-этилфенилсульфата, а введение 4-этилфенилсульфата здоровым мышам вызывало у них тревожное поведение, часто сопровождающее болезни аутического спектра.
Таким образом, авторы исследования продемонстрировали, что количество бактерий определенного типа в кишечнике влияет на уровень определенного вещества с крови, а это вещество, введенное само по себе, вызывает характерные изменения в поведении. Правда, праздновать победу над аутизмом пока рано. Во-первых, даже в этом отдельном случае механизмы еще не вполне ясны, а, во-вторых, аутизм, скорее всего, неоднородное по своей природе заболевание, и у разных людей может вызываться разными факторами.